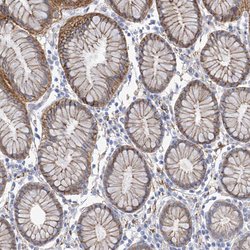

Learn More
ITGA9, Polyclonal, Invitrogen™
Rabbit Polyclonal Antibody
Supplier: Thermo Scientific PA556523
Description
This gene encodes an alpha integrin. Integrins are heterodimeric integral membrane glycoproteins composed of an alpha chain and a beta chain that mediate cell-cell and cell-matrix adhesion. The protein encoded by this gene, when bound to the beta 1 chain, forms an integrin that is a receptor for VCAM1, cytotactin and osteopontin. Expression of this gene has been found to be upregulated in small cell lung cancers.
Immunogen sequence: VITVDVSIFL PGSINITAPQ CHDGQQPVNC LNVTTCFSFH GKHVPEEIGL NYVLMADVAK KEKGQMPRVY FVLLGETMGQ VTEKLQLTYM EETCRHYVAH VKHighest antigen sequence identity to the following orthologs: Mouse - 83%, Rat - 85%.
Specifications
| ITGA9 | |
| Polyclonal | |
| PBS with 40% glycerol and 0.02% sodium azide; pH 7.2 | |
| Q13797 | |
| ITGA9 | |
| Recombinant protein corresponding to Human ITGA9 | |
| 100 μL | |
| Primary | |
| Human | |
| Antibody | |
| IgG |
| Immunocytochemistry, Immunofluorescence, Immunohistochemistry | |
| Unconjugated | |
| ITGA9 | |
| ALPHA-RLC, ITGA4L, RLC, integrin alpha-9, integrin alpha-RLC | |
| Rabbit | |
| Antigen affinity chromatography | |
| RUO | |
| 3680 | |
| Store at 4°C short term. Store at −20°C long term. Avoid freeze/thaw cycles. | |
| Liquid |
Your input is important to us. Please complete this form to provide feedback related to the content on this product.
Research Use Only